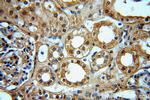
Pinin Antibody in Immunohistochemistry (Paraffin) (IHC (P))

Search
Proteintech
Pinin Polyclonal Antibody
{{$productOrderCtrl.translations['antibody.pdp.commerceCard.promotion.promotions']}}
{{$productOrderCtrl.translations['antibody.pdp.commerceCard.promotion.viewpromo']}}
{{$productOrderCtrl.translations['antibody.pdp.commerceCard.promotion.promocode']}}: {{promo.promoCode}} {{promo.promoTitle}} {{promo.promoDescription}}. {{$productOrderCtrl.translations['antibody.pdp.commerceCard.promotion.learnmore']}}
产品信息
18266-1-AP
种属反应
已发表种属
宿主/亚型
分类
类型
抗原
偶联物
形式
浓度
规格
纯化类型
保存液
内含物
保存条件
运输条件
产品详细信息
Immunogen sequence: EKQQDSQPE EVMDVLEMVE NVKHVIADQE VMETNRVESV EPSENEASKE LEPEMEFEIE PDKECKSLSP GKENVSALDM EKESEEKEEK ESEPQPEPVA QPQPQSQPQL QLQSQSQPVL QSQPPSQPED LSLAVLQPTP QVTQEQGHLL PERKDFPVES VKLTEVPVEP VLTVHPESKS KTKTRSRSRG RARNKTSKSR SRSSSSSSSS SSSTSSSSGS SSSSGSSSSR SSSSSSSSTS GSSSRDSSSS TSSSSESRSR SRGRGHNRDR KHRRSVDRKR RDTSGLERSH KSSKGGSSRD TKGSKDKNSR SDRKRSISES SRSGKRSSRS ERDRKSDRKD KRR (376-717 aa encoded by BC062602)
靶标信息
Transcriptional activator binding to the E-box 1 core sequence of the E-cadherin promoter gene; the core-binding sequence is 5'CAGGTG-3'. Capable of reversing CTBP1-mediated transcription repression. Auxiliary component of the splicing-dependent multiprotein exon junction complex (EJC) deposited at splice junction on mRNAs. The EJC is a dynamic structure consisting of core proteins and several peripheral nuclear and cytoplasmic associated factors that join the complex only transiently either during EJC assembly or during subsequent mRNA metabolism. Participates in the regulation of alternative pre-mRNA splicing. Associates to spliced mRNA within 60 nt upstream of the 5'-splice sites. Component of the PSAP complex which binds RNA in a sequence-independent manner and is proposed to be recruited to the EJC prior to or during the splicing process and to regulate specific excision of introns in specific transcription subsets. Involved in the establishment and maintenance of epithelia cell-cell adhesion. Potential tumor suppressor for renal cell carcinoma. [UniProt]
仅用于科研。不用于诊断过程。未经明确授权不得转售。
生物信息学
蛋白别名: 140 kDa nuclear and cell adhesion-related phosphoprotein; Desmosome-associated protein; Domain-rich serine protein; DRS protein; Melanoma metastasis clone A protein; neutrophil protein; Nuclear protein SDK3; Pinin; SR-like protein; unnamed protein product
基因别名: DRS; DRSP; MEMA; PNN; SDK3
UniProt ID: (Human) Q9H307
Entrez Gene ID: (Human) 5411